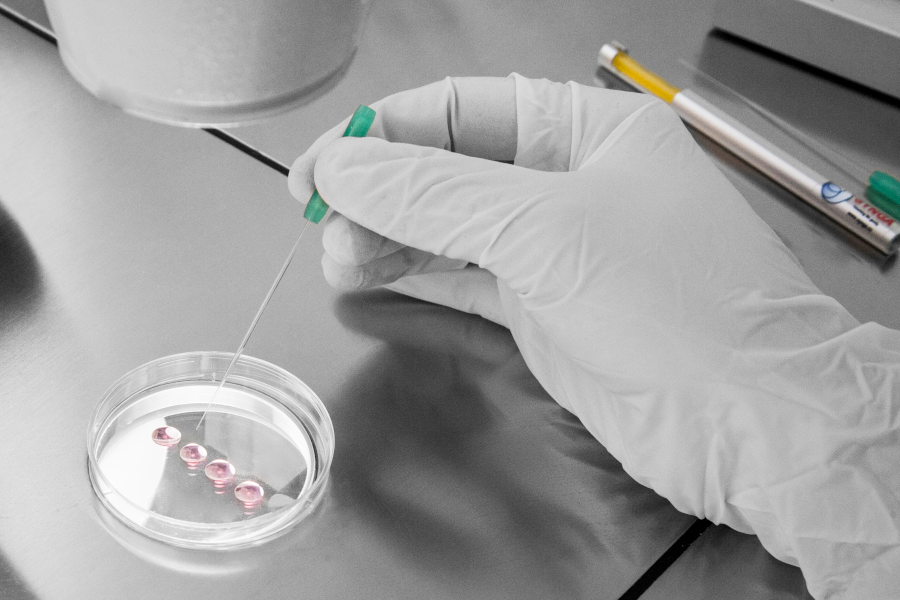

Glass Pipettes - Denudation
Denudation Pipettes
sharp opening, length tolerance +- 3 mmDiameter 140 µm
| without bulbs | with bulbs | |||
|---|---|---|---|---|
| Soft bulbs | VI bulbs | |||
| Ref No. SG-140S-50 | Ref No. SG-140S-20s | Ref No. SG-140S-20vi | ||
| Ref No. SG-140L-50 | Ref No. SG-140L-20s | Ref No. SG-140L-20vi | ||
| Ref No. SG-145S-50 | ||||
| Samples | ||||
| Ref No. SG-140S-10ms+vi | Ref No. SG-140S-5s | Ref No. SG-140S-5vi | ||
| Ref No. SG-140L-10ms+vi | Ref No. SG-140L-5s | Ref No. SG-140L-5vi | ||
|
S in ref. No means short, 14mm functional part of the pipette, less view but more stiff L in ref. No means long, 29mm functional part of the pipette, better view but more flexible | ||||

Usage
- final cleaning of smaller oocytes in denudation (after previous partial removal of coronal cells using a pipette of diameter 150 µm)
- can be used in final step of vitrificaion, when it is important to transfer the oocyte, or hatching embryo, in minimal volume of vitrification solution
Diameter 130 µm
| without bulbs | with bulbs | |||
|---|---|---|---|---|
| Soft bulbs | VI bulbs | |||
| Ref No. SG-130S-50 | Ref No. SG-130S-20s | Ref No. SG-130S-20vi | ||
| Ref No. SG-130L-50 | Ref No. SG-130L-20s | Ref No. SG-130L-20vi | ||
| Samples | ||||
| Ref No. SG-130S-10ms+vi | Ref No. SG-130S-5s | Ref No. SG-130S-5vi | ||
| Ref No. SG-130L-10ms+vi | Ref No. SG-130L-5s | Ref No. SG-130L-5vi | ||
|
S in ref. No means short, 14mm functional part of the pipette, less view but more stiff L in ref. No means long, 29mm functional part of the pipette, better view but more flexible | ||||

Usage
- manipulation of cells after biopsy: better visual control and prevention of the sample getting stuck in the pipette
- manipulation of smaller animal (f.e. mouse) oocytes/embryos
Other denudation diameters
150 µm, 160 µm
